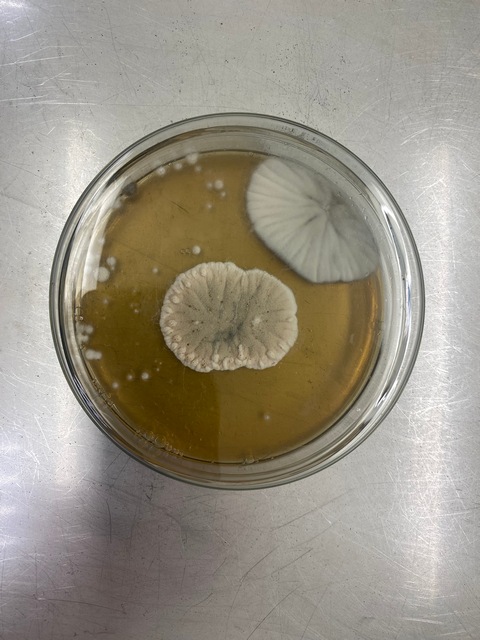

24. ГБУ Брянской области "Клинцовская зональная ветеринарная лаборатория"
Директор - Виниченко Татьяна Викторовна
Адрес: 243140, Брянская обл., Клинцовский р-н, г. Клинцы, п/о Вьюнки, ул. Придорожная, д. 18
тел. (48336) 5-27-88
e-mail: Этот адрес электронной почты защищен от спам-ботов. У вас должен быть включен JavaScript для просмотра.
Официальная страница в социальной сети: Вконтакте
Лейкоз КРС

Лейкоз – хроническая инфекционная болезнь опухолевой природы, протекающая бессимптомно или характеризующаяся лимфоцитозом и злокачественным разрастанием кроветворных и лимфоидных клеток в различных органах.
Лейкоз диагностируют почти во всех странах мира, особенно в районах с хорошо развитым племенным скотоводством. В России встречается во всех регионах.
Пироплазмидозы

Пироплазмидозы домашних животных наносят большой ущерб животноводству. Они резко снижают продуктивность животных. Немало скота погибает от этих болезней. При анаплазмозе и тейлериозе падеж крупного рогатого скота может достигать 40%.
Пироплазмидозы обостряют течение некоторых инфекционных хронических болезней (пироплазмоз + инфекционная анемия). Пироплазмидозы тормозят улучшение племенных качеств местного скота. Завоз племенных животных в районы, неблагополучные по пироплазмидозам жвачных, связан со значительным риском ввиду возможности тяжелого переболевания их этими болезнями. Животные могут заболеть пироплазмидозами при наличии трех звеньев эпизоотологической цепи: больных животных или паразитоносителей, специфических видов иксодовых клещей (переносчиков пироплазмид) и восприимчивых животных. При отсутствии или выключении одного из звеньев этой триады инвазии (эпизоотологической цепи) животные пироплазмидозами не заболевают. В зависимости от эпизоотологических особенностей различают энзоотический, латентный, угрожаемый очаги и благополучные территории.
Болезнь Лайма (боррелиоз)

Из-за раннего потепления начался сезон клещей. Болезнь Лайма (также известная под названием иксодовый клещевой боррелиоз) — опасное заболевание инфекционного характера, с несколькими стадиями развития. Болезнь распространяется через основных переносчиков, несущих опасность для человека, — иксодовых клещей. Заболевание имеет природный характер. Инфекция появляется у разных домашних и диких животных.
Иксодовые клещи — это мелкие кровососущие животные, имеющие темно-коричневый окрас. С первого взгляда он может напомнить высохший слой кожи на ранке либо каплю грязи. Средняя продолжительность жизни иксодовых клещей составляет 24 месяца (очень редко — немного больше). Селятся они на кустарниковых растениях, не более 1 метра над поверхностью земли. Зимовка — весьма сложный процесс для этих животных, выживают после холодов только самки.
Коагулазоположительные стафилококки и Staphylococcus aureus

В ГБУ Брянской области «Клинцовская зональная ветлаборатория» поступают пробы для исследования на стафилококки. В основном пробы молочной продукции (молока питьевого пастеризованного, творога, масла сливочного) и рыбы живой. Исследования проводятся по ГОСТ 30347 - 2016 "Молоко и молочная продукция. Методы определения Staphylococcus aureus" ГОСТ 31746-2012 "Продукты пищевые. Методы выявления и определения количества коагулазоположительных стафилококков и Staphylococcus aureus". Для подтверждения правильности применения метода испытаний специалисты участвовали в проверке квалификации путем проведения межлабораторных сличительных испытаний. Результаты были признаны удовлетворительными.
Подробнее: Коагулазоположительные стафилококки и Staphylococcus aureus
Инфекционная анемия лошадей

Инфекционная анемия – ИНАН – остро и хронически протекающая болезнь однокопытных, характеризующаяся нарушением функции сердечно-сосудистой системы, упадком сил и длительным вирусоносительством.
Инфекционная анемия лошадей (ИНАН) относится к одним из наиболее опасных заболеваний.
Инфекционной анемией болеют лошади всех возрастов, ослы и мулы. У жеребят болезнь часто заканчивается смертью.
Дерматомикозы
Участились случаи обращения владельцев мелких домашних животных в ГБУ Брянской области «Клинцовская зональная ветлаборатория» с заболеванием собак и кошек дерматомикозами. Дерматомикозы у животных (трихофития, микроспория) - заразные инфекционные заболевания кожи и ее производных, вызываемые патогенными грибками-дерматофитами. Они поражают кожный покров, волосяные фолликулы, сами волосы, а также когти (онихомикоз), которые становятся толстыми и деформированными.
Основным источником возбудителя микроспории служат больные и переболевшие кошки, реже – лисы, собаки, лошади, кролики, морские свинки и шиншиллы.
Лейкоцитарная формула

В ходе проведения клинического анализа крови исследуется окрашенный мазок на предмет выявления соотношения различных форм лейкоцитов в крови. Данные показатели могут быть типичными для отдельных заболеваний. Расшифровка лейкоцитарной формулы возможна на основе нижеследующих сведений.
Сап

Сап (malleus) – инфекционная болезнь однокопытных животных, характеризующаяся лихорадкой, истощением и развитием в паренхиматозных органах, чаще в легких, на слизистых оболочках и коже сапных узелков и язв.
Возбудитель болезни – Actinobacillus mallei, грамотрицательная, короткая, неподвижная, не образующая спор и капсул палочка с округленными краями бактерия. Во внешней среде малоустойчива. Культуры бактерии сапа выращивают на обыкновенных нейтральных питательных средах, содержащих 5% глицерина. Дезосредства в обычных концентрациях губительно действует на возбудителя. Антибиотики и сульфаниламидные препараты также губительно действуют на сапных бактерий.




























